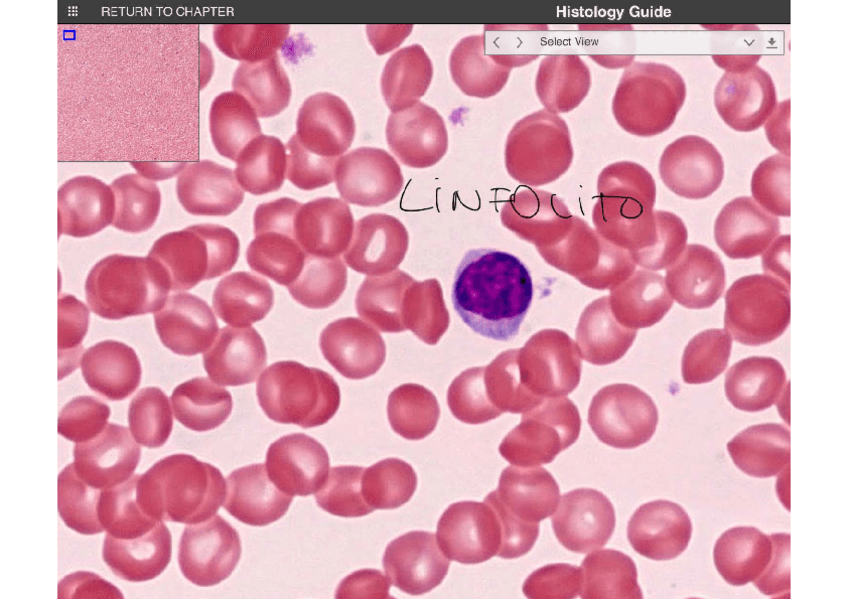

Citología e Histología
He publicado nuevos apuntes de 1º Citología e Histología: HISTOLOGIA-Y-CITOLOGIA.pdf
He publicado nuevos apuntes de 1º Citología e Histología: HISTOLOGIA-SISTEMAS-Y-APARATOS.pdf
apuntes
-
RIESGOS BIOLÓGICOS (curso)
He publicado nuevos apuntes de 1º Citología e Histología: RIESGOS BIOLÓGICOS (curso)
He publicado nuevos apuntes de 1º Citología e Histología: APUNTES-PRACTICAS-COMPLETOS.docx.pdf
apuntes
-
Citología e Histología
He publicado nuevos apuntes de 1º Citología e Histología: Citología e Histología
He publicado nuevos apuntes de 1º Citología e Histología: Practica-2-citologia.pdf
He publicado nuevos apuntes de 1º Citología e Histología: Practica-3-citologia.pdf
practicas
-
Prácticas Citología
He publicado nuevos practicas de 1º Citología e Histología: Prácticas Citología
apuntes
-
Citología e Histología
He publicado nuevos apuntes de 1º Citología e Histología: Citología e Histología
He publicado nuevos apuntes de 1º Citología e Histología: Histologia-de-aparatos-y-sistemas.pdf
He publicado nuevos apuntes de 1º Citología e Histología: Histologia-Basica.pdf
He publicado nuevos apuntes de 1º Citología e Histología: Citologia-y-Desarrollo-Humano.pdf
He publicado nuevos apuntes de 1º Citología e Histología: Introduccion-y-tecnicas-histologicas-citologia.pdf
He publicado nuevos apuntes de 1º Citología e Histología: Bloque-IV-.-Aparatos-y-sistemas.pdf
He publicado nuevos apuntes de 1º Citología e Histología: Bloque-III-tejidos-completo.pdf
He publicado nuevos apuntes de 1º Citología e Histología: Histologia-practicas-apuntes-completos.pdf
He publicado nuevos apuntes de 1º Citología e Histología: Apuntes-practica-2-citologia.pdf
He publicado nuevos apuntes de 1º Citología e Histología: Unidad-3.-Histologia-General-Isabel-Higueras-Fisioterapia.pdf
apuntes
-
Citología e Histología
He publicado nuevos apuntes de 1º Citología e Histología: Citología e Histología
apuntes
-
Apuntes Citología e Histología
He publicado nuevos apuntes de 1º Citología e Histología: Apuntes Citología e Histología
apuntes
-
Citología e Histología, Teoría + Prácticas
He publicado nuevos apuntes de 1º Citología e Histología: Citología e Histología, Teoría + Prácticas
He publicado nuevos apuntes de 1º Citología e Histología: Completo-teoria.pdf
apuntes
-
CITOLOGÍA E HISTOLOGÍA
He publicado nuevos apuntes de 1º Citología e Histología: CITOLOGÍA E HISTOLOGÍA
apuntes
-
Asignatura completa. Mejor nota
He publicado nuevos apuntes de 1º Citología e Histología: Asignatura completa. Mejor nota
apuntes
-
Citología e Histología Eduardo Segura
He publicado nuevos apuntes de 1º Citología e Histología: Citología e Histología Eduardo Segura
apuntes
-
CITOLOGÍA E HISTOLOGÍA PDF
He publicado nuevos apuntes de 1º Citología e Histología: CITOLOGÍA E HISTOLOGÍA PDF
apuntes
-
apuntes por temas
He publicado nuevos apuntes de 1º Citología e Histología: apuntes por temas
apuntes
-
EXAMENES
He publicado nuevos apuntes de 1º Citología e Histología: EXAMENES
apuntes
-
EXAMENES CITOLOGIA
He publicado nuevos apuntes de 1º Citología e Histología: EXAMENES CITOLOGIA
He publicado nuevos apuntes de 1º Citología e Histología: APUNTES-HISTOLOGIA.pdf
He publicado nuevos apuntes de 1º Citología e Histología: Histologia-primero-fisioterpaia.pdf
He publicado nuevos apuntes de 1º Citología e Histología: TEJIDO ADIPOSO.docx
He publicado nuevos apuntes de 1º Citología e Histología: TEJIDOS ESQUELETÓGENOS I.docx
He publicado nuevos apuntes de 1º Citología e Histología: EPITELIOS DE REVESTIMIENTO.docx
He publicado nuevos apuntes de 1º Citología e Histología: Test_respuestas cito e histo.pdf

¡Estás al día!
Has visto todos los archivos